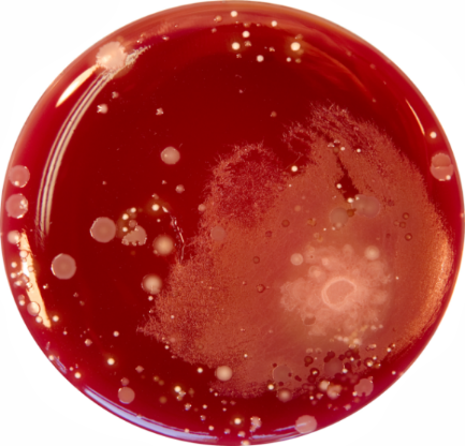
Wirksamkeit der Händehygiene - vorher

Informationen zur Händehygiene
Indikationen zur Händehygiene
- vor Betreten und nach Verlassen des Patientenzimmers Händedesinfektion durchführen
- vor Nutzung des Trinkwasserspenders Händedesinfektion durchführen
- vor Betreten der Toilette Händedesinfektion durchführen
- nach Toilettennutzung Händewaschen und anschließende Händedesinfektion durchführen
3 Gute Gründe dafür



Wie wirksam eine gründliche Händehygiene ist, zeigt ein Blick auf die Abdruckprobe.
Hände vor der Desinfektion
Hände nach der Desinfektion